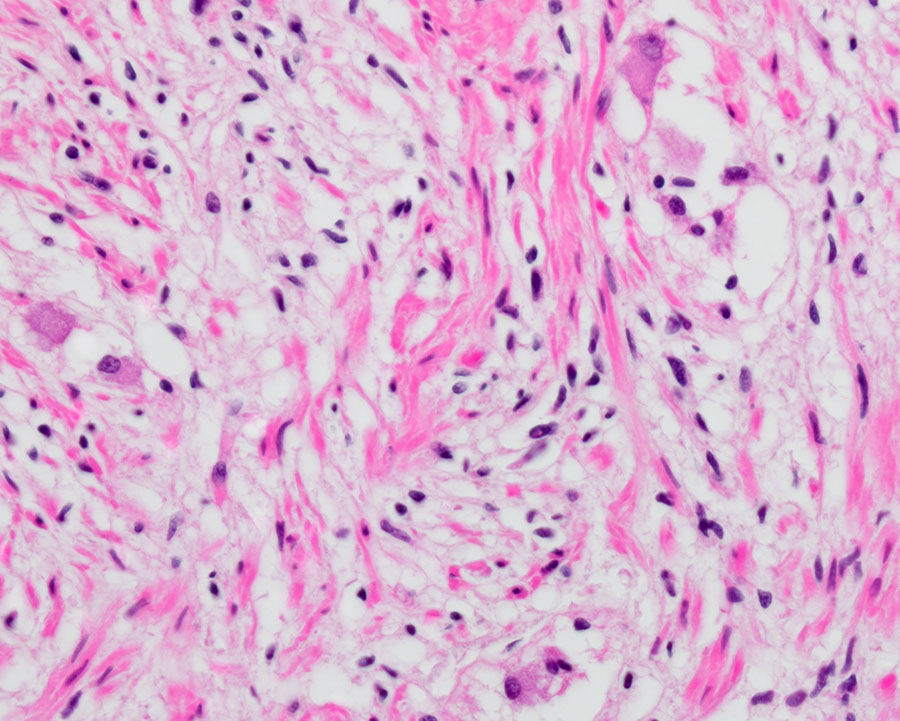

Case of the Month: Appendiceal Lesion
By Phoenix D. Bell (PGY-3), MD, MS, Aaron R. Huber, DO, Christa L. Whitney-Miller, MD, Leon Metlay, MD
Clinical History
An elderly male with a past medical history of stroke, prostate cancer, hypertension, and hyperlipidemia presents for postmortem examination.
Recent History
Twelve days prior to his passing, the patient was admitted for management of a stroke and concomitant pneumonia, hypotension, and acute kidney injury. During his hospital stay, the patient developed multiple pulmonary emboli which, in combination with his pneumonia, eventually led to his death. During postmortem examination, an unremarkable vermiform appendix with a tan-pink, glistening serosal surface was identified.
Microscopic examination of the appendix demonstrated a well-circumscribed lesion within the appendiceal wall (Figure 1A). The lesion was predominantly composed of a proliferation of cells with amphophilic to clear cytoplasm and bland spindled to wavy nuclei (Figure 1B). There were also scattered larger cells with abundant eosinophilic cytoplasm, some with granular cytoplasmic pigment, and eccentrically placed round nuclei with vesicular chromatin and prominent nucleoli (Figure 1C). No mitotic figures or cytologic atypia were identified. Immunohistochemical analysis showed the spindled cells and larger cells were highlighted by S-100 protein (Figure 1D), while only the larger cells were positive for synaptophysin (Figure 1E).